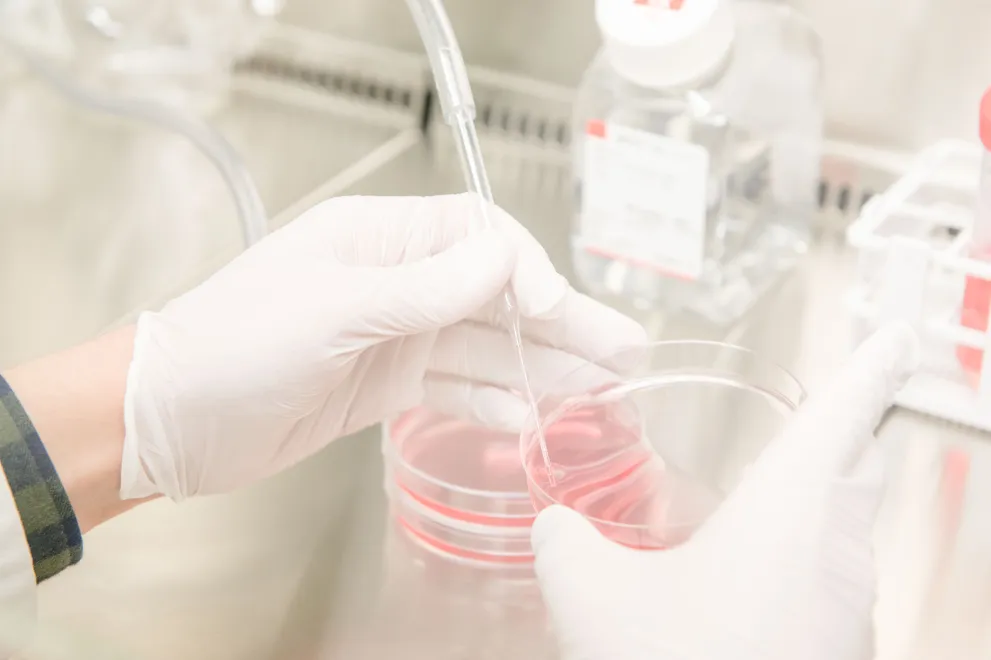
Zellkultur

Die acht medizinischen Fakultäten der Universitäten in Nordrhein-Westfalen haben sich zu einem 3R-Kompetenznetzwerk zusammengeschlossen. Im Sinne des 3R-Prinzips möchte das Netzwerk (bio-) medizinischen Fortschritt in NRW im Einklang mit bestem Tierschutz ermöglichen und gezielt die Forschung, Innovation und Ausbildung auf dem Gebiet fördern.
Netzwerkkoordinatorin am Standort Bochum ist Susanne Scheffner.